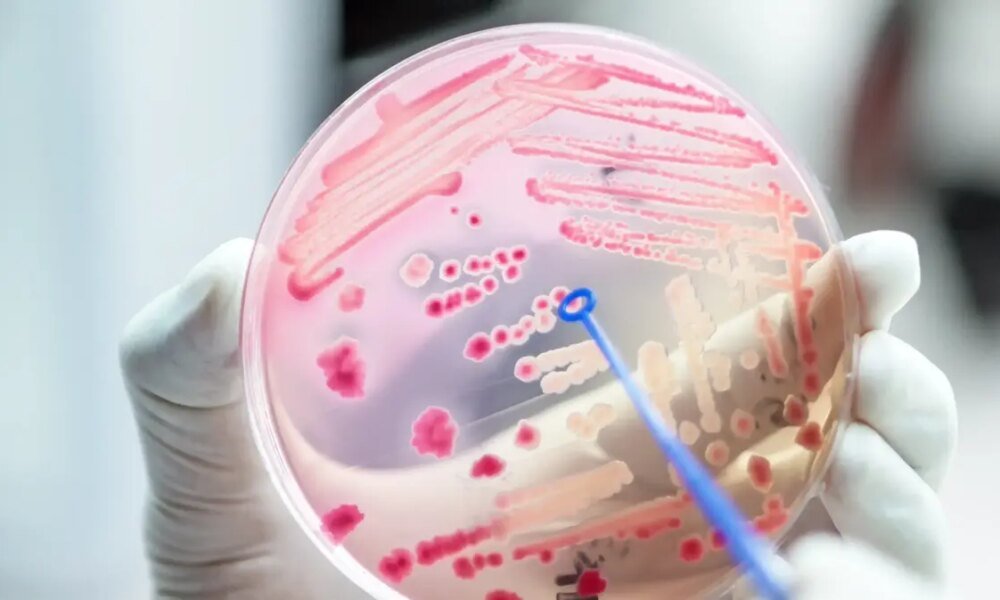
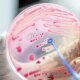

עם זאת, לתפריט הביצים היו גם השלכות פחות חיוביות. מחקרים קודמים מצביעים על כך שחלקיקים קטנים וצפופים של LDL מסוכנים יותר ללב. ובכן, בדיוק את סוגי...



רופא אונליין הוא כבר חלק בלתי נפרד מנוף הרפואה הישראלית, אך חיל הרפואה סירב במשך שנים לאפשר את השירות למשרתים, מהחשש שהחיילים יעשו...



מהפכה רפואית עתידנית מתרחשת בחודשים האחרונים ברחבי מערכת הבריאות בישראל: מציאות מדומה, שבעבר שימשה בעיקר בתחום המשחקים נכנסת כעת בעוצמה לחדרי הטיפולים, הצינתורים...



כמה פעמים מצאתם את עצמכם, אחרי פרוסת עוגה או ארוחה גדולה מהמתוכנן, אומרים לעצמכם משפטים כמו "הרסתי הכול" או "אני תמיד נכשלת"? נשמע אולי "לא ביג...

בתוך בתי החולים, יש חיידקים שמצליחים "לשרוד" גם מול אנטיביוטיקות חזקות. לא כולם מסוכנים באותה מידה אבל כולם מחייבים התייחסות רצינית. להלן מספר דוגמאות: MRSAחיידק עמיד...



לא מעט משפיעני בריאות וכושר ממליצים לשתות את המיץ של החמוצים. אז למה כדאי לחשוב פעמיים לפני שמצטרפים אליו? Source link



"במובן של טיפול, סטטינים, שהם התרופה הסטנדרטית לבקרת כולסטרול, ידועים גם כמורידי רמות hs-CRP", אומר ד"ר קשאווה. "אז גם אם רמות הכולסטרול שלכם נמצאות בטווח הנורמלי,...



התסמינים הפיזיים לא איחרו להגיע: כאבי גב, צוואר וכתפיים הפכו לשגרה, והיא נזקקה לעיתים לכיסא גלגלים. אפילו פעולות פשוטות כמו לקשור שרוכים, לגזור ציפורניים או לנעול...



במסגרת המערכת פועלת אחות יועצת פצעים המובילה הכשרות מקצועיות, ובכל מחלקה מכשירים נאמנים מובלים את הצוות להתמקצעות בתחום. כמו כן, רכש בית החולים מכשיר חדשני לטיפול...



מגפת החצבת משתוללת באזור ירושלים ומאיימת על חיי הפעוטות הלא מחוסנים: שני ילדים מירושלים ומבית שמש מאושפזים במצב אנוש בבית החולים הדסה עין...